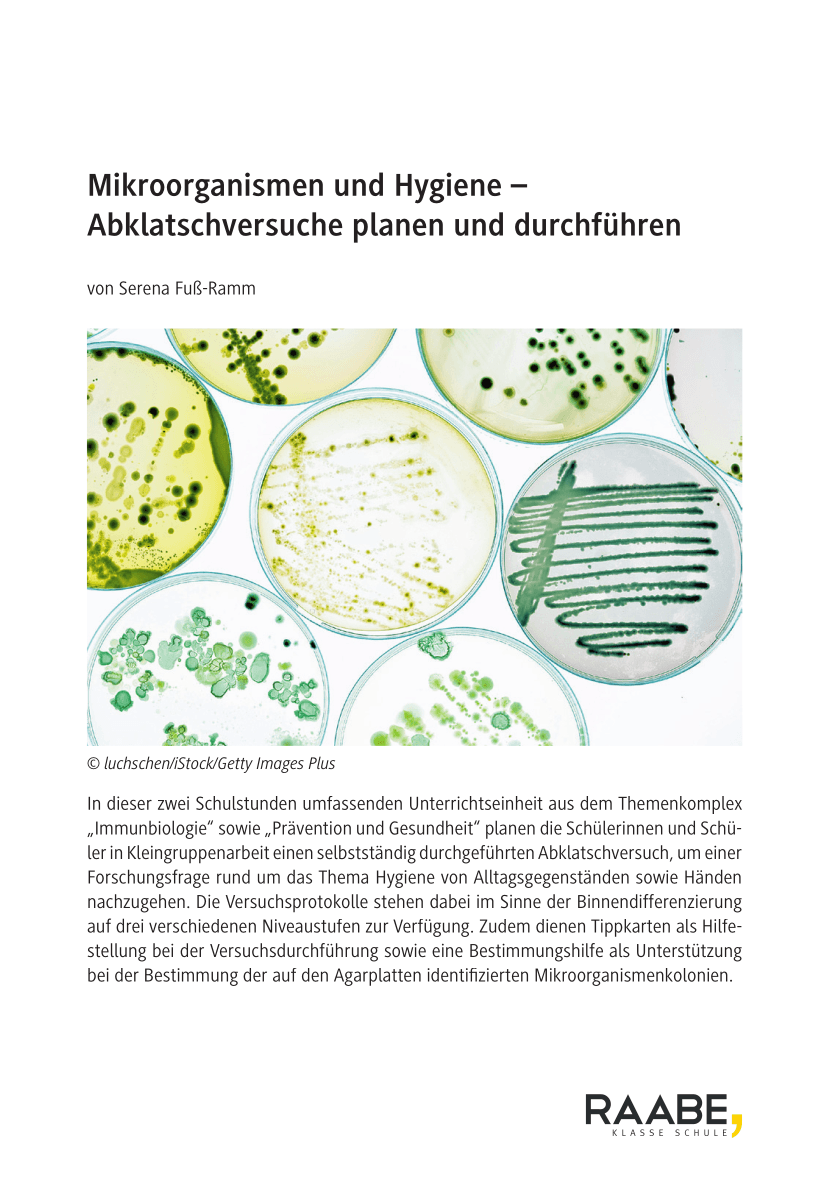

Berufliche Schulen | Gymnasium | Mittlere Schulformen
Biologie
8. | 9. Klasse
2 Unterrichtsstunden
Beschreibung
In dieser zwei Schulstunden umfassenden Unterrichtseinheit aus dem Themenkomplex „Immunbiologie“ sowie „Prävention und Gesundheit“ planen die Schülerinnen und Schüler in Kleingruppenarbeit einen selbstständig durchgeführten Abklatschversuch, um einer Forschungsfrage rund um das Thema Hygiene von Alltagsgegenständen sowie Händen nachzugehen. Die Versuchsprotokolle stehen dabei im Sinne der Binnendifferenzierung auf drei verschiedenen Niveaustufen zur Verfügung. Zudem dienen Tippkarten als Hilfe-stellung bei der Versuchsdurchführung sowie eine Bestimmungshilfe als Unterstützung bei der Bestimmung der auf den Agarplatten identifizierten Mikroorganismenkolonien.
# Immunbiologie
# Mikrobiologie
# Hygiene
# Bau und Vermehrung von Bakterien und Viren
# Mikroorganismen
# Bakterien
# Pilze
# Abklatschversuche
# Experimentelles Arbeiten
# Prävention und Gesundheitsförderung